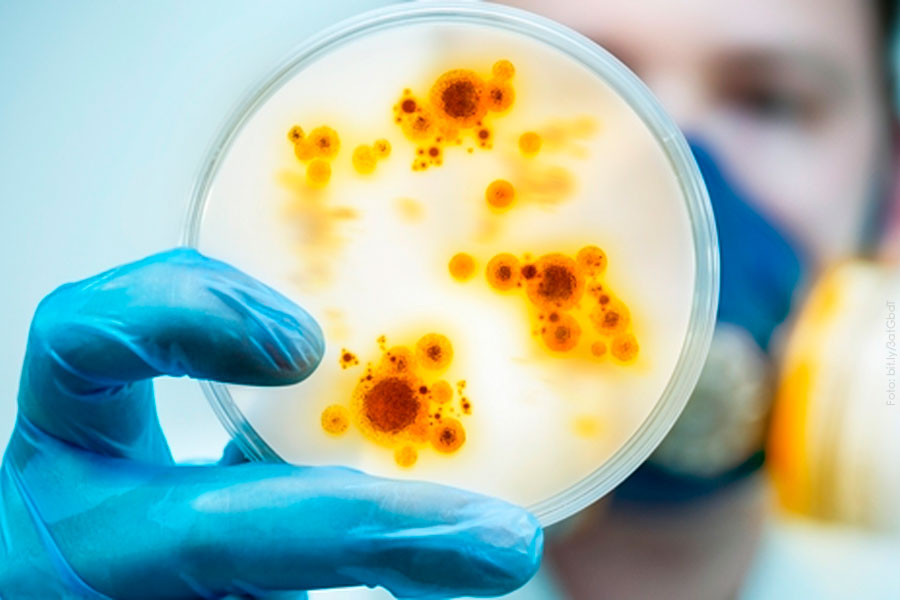

Son producto de la actividad humana
La modificación de los patrones de distribución de especies, inducida, sobre todo, por actividades humanas, tiene un papel fundamental en su aparición
Roberto Gutiérrez Mar 12, 2020
En todo el mundo hay virus, bacterias, protozoarios y parásitos, y si por algún motivo sus hospederos, reservorios y vectores cambian de sitio, surgen escenarios en los que se genera el intercambio de estos microorganismos entre diferentes especies, lo cual resulta muy común en la naturaleza.
“En el caso de muchas enfermedades emergentes –es decir, las que son causadas por un agente infeccioso recién identificado–, la modificación de los patrones de distribución de especies, inducida, sobre todo, por actividades humanas como el cambio climático, la deforestación, el cambio de uso del suelo y la introducción de especies exóticas, tiene un papel fundamental en su aparición”, afirmó Gerardo Suzán Azpiri, investigador del Departamento de Etología, Fauna Silvestre y Animales de Laboratorio de la Facultad de Medicina Veterinaria y Zootecnia.
En opinión del universitario, el uso desmedido de antibióticos es otro factor que está propiciando que diversos agentes patógenos desarrollen resistencia a ellos, cambien sus factores de virulencia y ocasionen enfermedades emergentes o reemergentes en distintas poblaciones humanas.
“Las reemergentes son aquellas afecciones cuyas tasas de infección y mortalidad permanecían en niveles bajos y de pronto suben a niveles muy altos, por lo general como consecuencia de estos cambios que se dan en los agentes patógenos”, apuntó.

Fauna silvestre y animales domésticos
Casi todas las zoonosis (enfermedades compartidas por personas y animales) tienen su origen en animales silvestres, pero algunas como la brucelosis y la tuberculosis se originan por el contacto con animales domésticos como vacas, cabras, borregos…
“Ahora, con la deforestación y la pérdida de los ecosistemas, no pocas de las zoonosis son compartidas por animales tanto domésticos como silvestres, y los humanos”, comentó Suzán Azpiri.
Entre los padecimientos emergentes transmitidos por fauna silvestre que han sido estudiados en México están la leishmaniasis (roedores y pequeños mamíferos), la trypanosomiasis americana o enfermedad de Chagas (roedores, tlacuaches y perros ferales) y la rabia (carnívoros silvestres, así como y murciélagos hematófagos).
“Hay otros emergentes, como la toxoplasmosis (gatos), la leptospirosis (cerdos, vacas, ratas y mapaches), la bartonelosis (sobre todo gatos) y la tularemia (roedores, conejos y liebres), que ya representan un problema en el sur de Estados Unidos y a las que no les hemos dedicado estudios sistemáticos en México para saber cuál es la dinámica de la fauna silvestre que las transmite”, indicó.
Con respecto al síndrome pulmonar por Hantavirus, que es transmitido por roedores silvestres asociados a cultivos, resulta muy común en el vecino país del norte. En México, el investigador de la UNAM y sus colaboradores han detectado el Hantavirus en roedores silvestres de distintas partes del territorio (en Hidalgo tiene una alta prevalencia), pero ignoran a cuántas personas ha infectado.
Asimismo, la enfermedad por el virus del oeste del Nilo, que es transmitida por aves, resulta muy común en Estados Unidos, si bien en México aparentemente no ha prendido en humanos.
“Este es un tema pendiente. Tenemos que investigar qué está sucediendo con las personas y el por qué no hemos detectado el virus del oeste del Nilo en ninguna parte, aunque sí en varias especies de aves en toda la nación.”

Peste bubónica, ricketsiosis y erliquiosis
La peste bubónica, que es transmitida por una pulga que llevan las ratas, las ardillas y ciertos carnívoros silvestres como los pumas, está presente en el sur de Estados Unidos, y según Suzán Azpiri, quizá lo esté también en Baja California, Sonora, Chihuahua, Coahuila, Nuevo León y Tamaulipas, estados fronterizos mexicanos.
En Mexicali, Baja California, y en localidades de Chihuahua ha habido recientemente una cantidad considerable de casos de ricketsiosis y erliquiosis, enfermedades emergentes transmitidas por una garrapata que llevan los perros ferales y otros carnívoros silvestres. Ya han causado la muerte de personas.
Zonas de riesgo
Las zonas donde se corre más riesgo de adquirir enfermedades emergentes transmitidas por mosquitos (chikungunya, dengue, zika, encefalitis equina venezolana…) se encuentran en el sur del país, especialmente en Chiapas.
“Sí, en esas zonas confluyen las condiciones propicias para que aparezca ese tipo de padecimientos: pobreza, marginación, pérdida de biodiversidad por la deforestación, introducción de especies exóticas…”, finalizó Suzán Azpiri.

—————————————
* Tomada de Gaceta UNAM. Publicada con fines no lucrativos. Si usted está interesado en estos temas, visite el sitio: https://www.gaceta.unam.mx/cambio-climatico-y-deforestacion-causa-de-enfermedades-emergentes-en-mexico/
